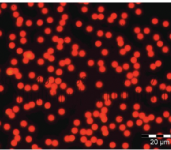
Fluoro-Max熒光微球 乾粉狀 紅色和綠色

- ☆ ★~歡迎您到留言版給我們加油打氣~☆ ★
- ☆ ★~歡迎光臨本站~☆ ★
染色和熒光微粒
分類名稱: 染色和熒光微粒
-

- ChromoSphere™ 染色聚合物微粒,乾粉狀
- 賽默飛世爾科技 Thermo Scientific™ ChromoSphere™ 染色微粒(乾粉)為聚合物微粒,在內部進行深度紅色或黑色染料的染色,這些強烈的顏色相對於大多數的背景材料形成強烈的對比與可見度。這類產品以乾粉形式提供,可很容易地按需懸浮於液體介質中。這一產品系列包括一系列大小均一的紅色或黑色微粒,直徑分佈於50 μm 至 500 μm 範圍內。
-

- Fluoro-Max 粒子標誌物 乾粉狀 心肌梗死研究
- Thermo Scientific™ Fluoro-Max 粒子標誌物是一種停留於毛細血管內的明亮的黃綠色微粒,在評估局部缺血時,能夠高效地標記“風險區”。這些微粒由含有特殊熒光染料的聚合物合成,使用手持式 UV 燈 (Wood’s Lamp) 即可有效激發這種熒光染料。它們為球狀,直徑 10 μm,密度為 1.05 g/cm3,這使得它們容易懸浮在水介質中。
-

- Fluoro-Max™ 熒光微球 Firefli 熒光綠 紅色 藍色
- 在比自身發散光波長短的激發光照射下,這種熒光微粒會發出明亮而清晰的顏色。相比較於背景材料,這大大提高了他們的對比度與可見度。
除了傳統顯微鏡的特點,熒光微粒為分析方法提供了更好的敏感性與可檢測性。這種熒光微粒是深度染色的(內部染色)聚合物微粒,它採用Firefli 合成方法將染料吸收入聚合物基質中。這種技術方法可產生明亮的熒光色,降低光褪色的可能性,並防止染料滲濾至液體介質中。
-
- Fluoro-Max熒光微球 乾粉狀 紅色和綠色
- 在採用比自身發散光波長更短的光的照射下,Fluoro-Max 熒光微粒可發散出明亮而清晰的顏色。相比較於背景材料,這會增強微粒的對比度與可見度。
除了傳統顯微鏡的特點,熒光微粒為分析方法提供了更好的敏感性與可檢測性。



.png)
.png)






.png)









